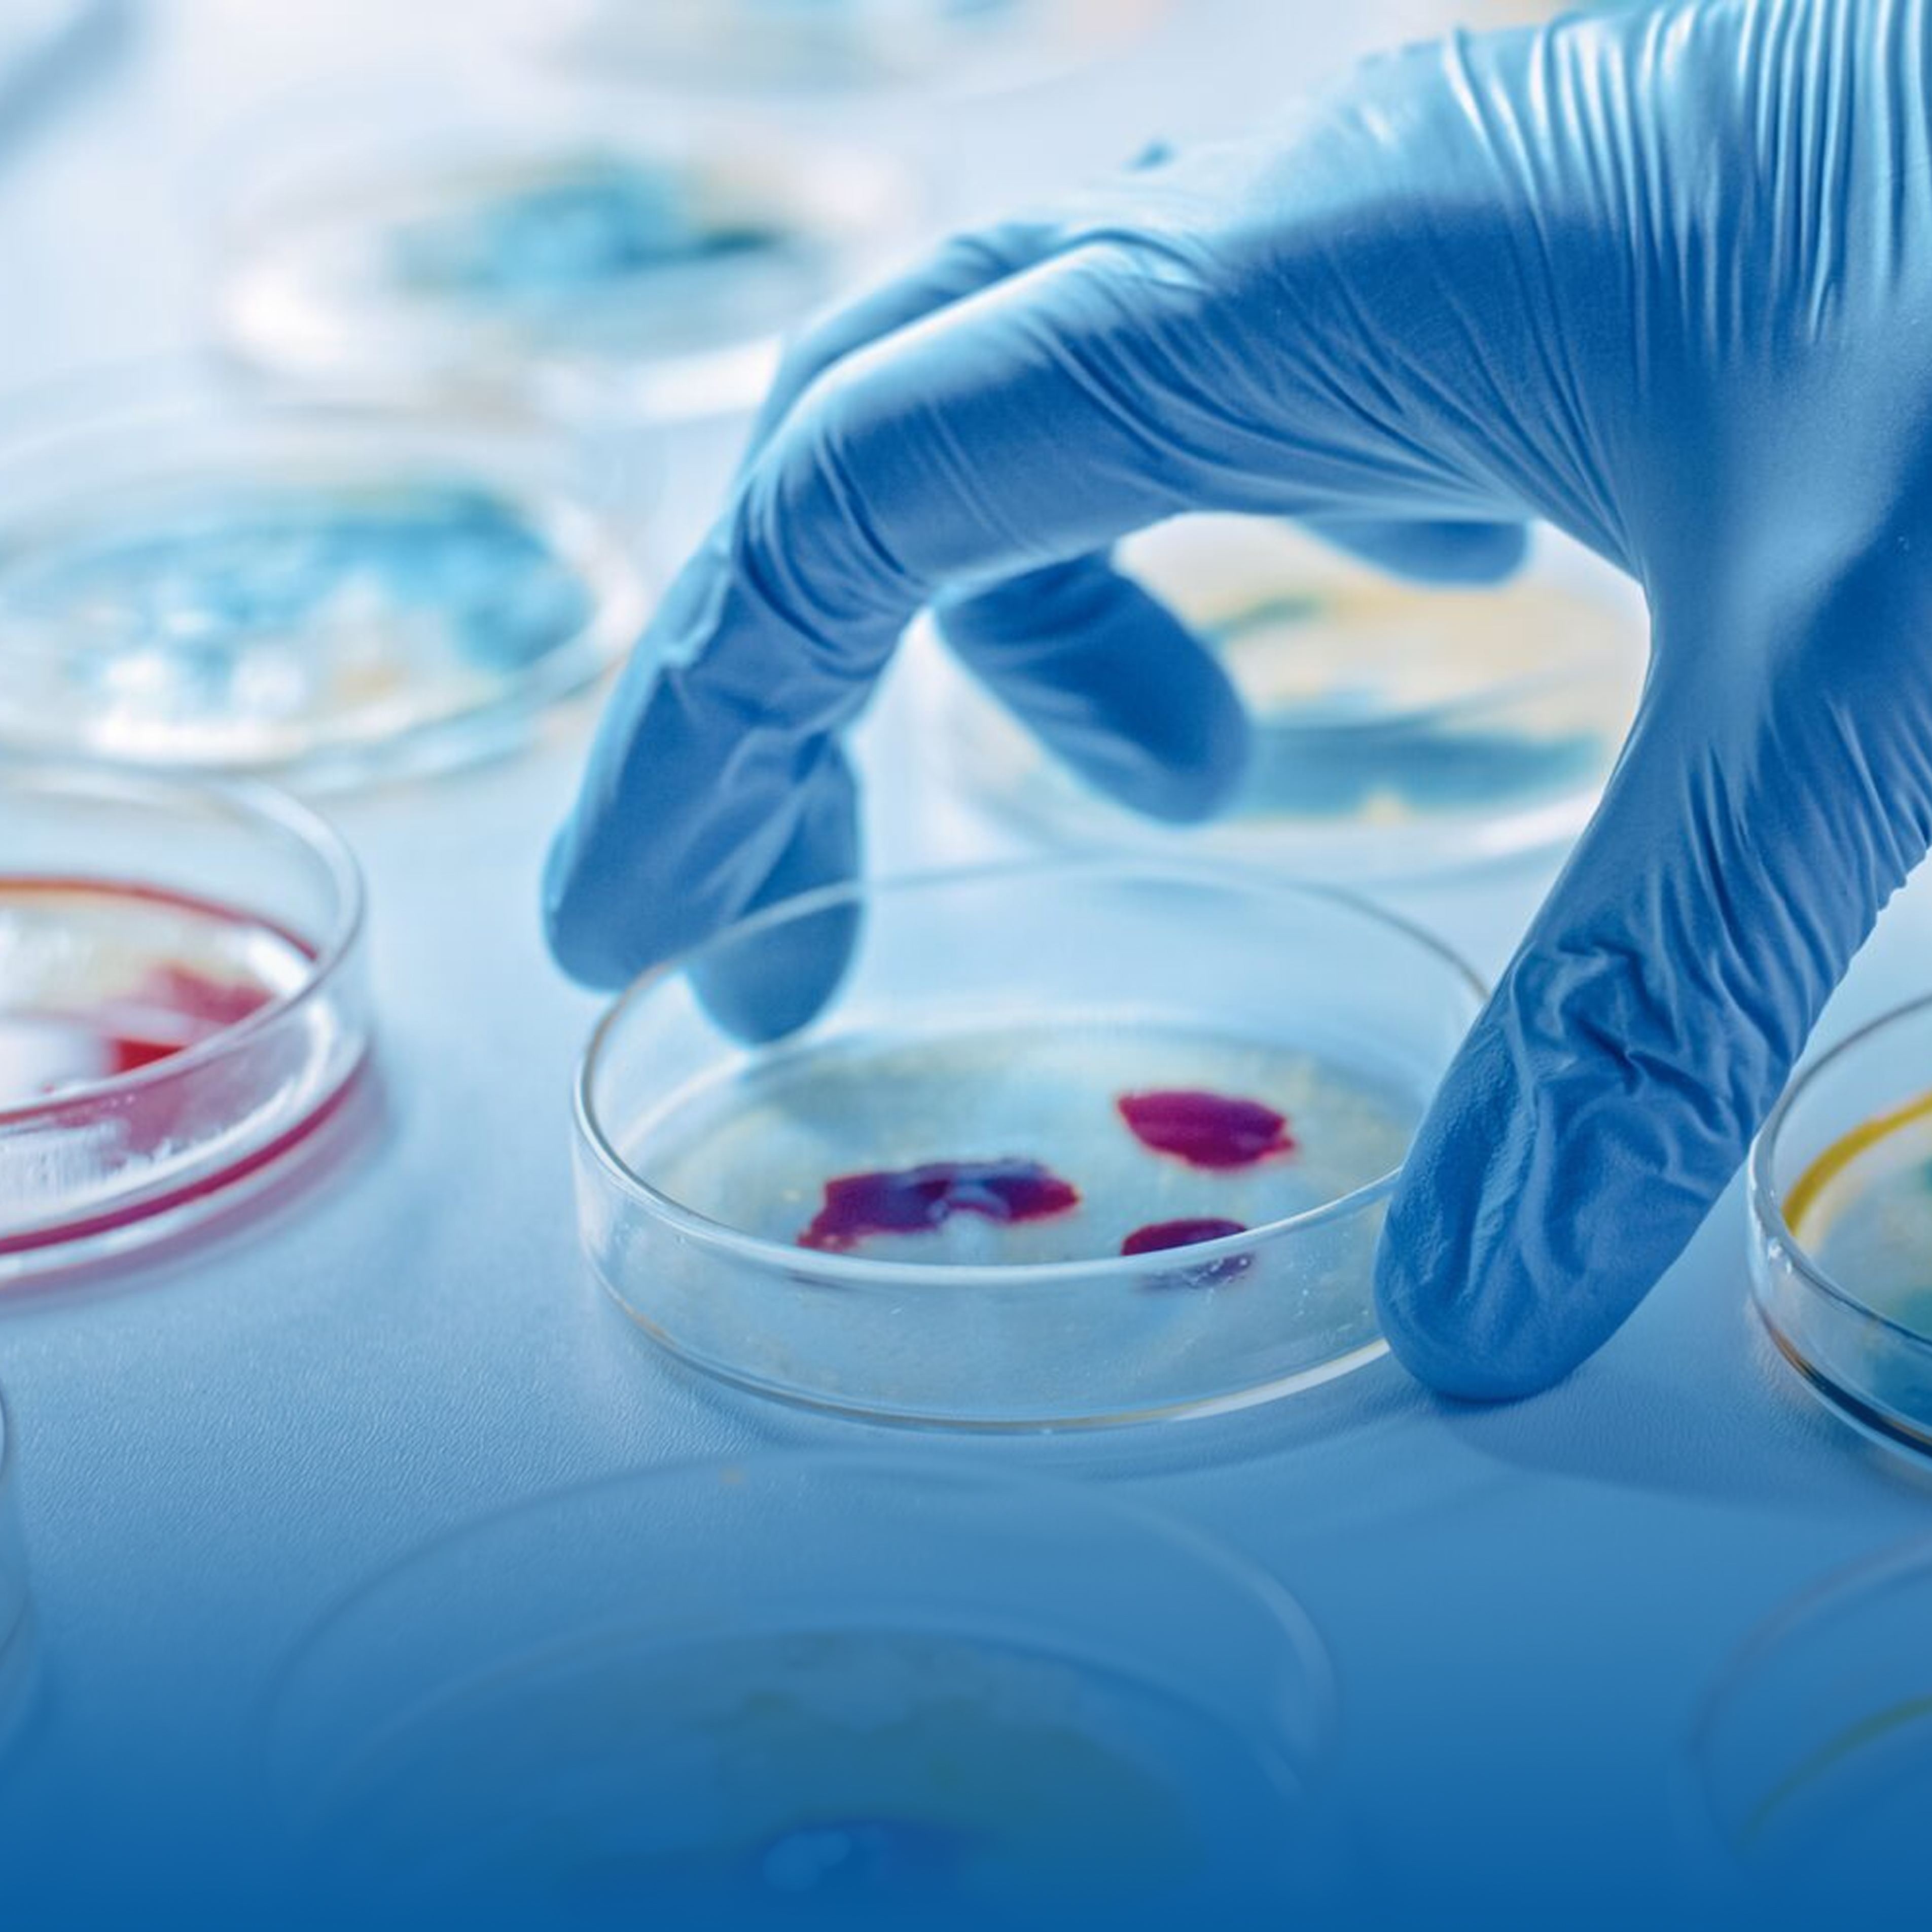
sq-sample32

Anaesthesiology

Anatomy

Bio-Chemistry

Community Medicine

Dentistry

Dermatology

ENT

Forensic Medicine

General Medicine

General Surgery

Gynecology
Micro Biology

Orthopedics

Paediatrics

Pathology

Pharmocology

Physiology

Psychiatry

Pulmonology

Radiology

Emergency Medicine

